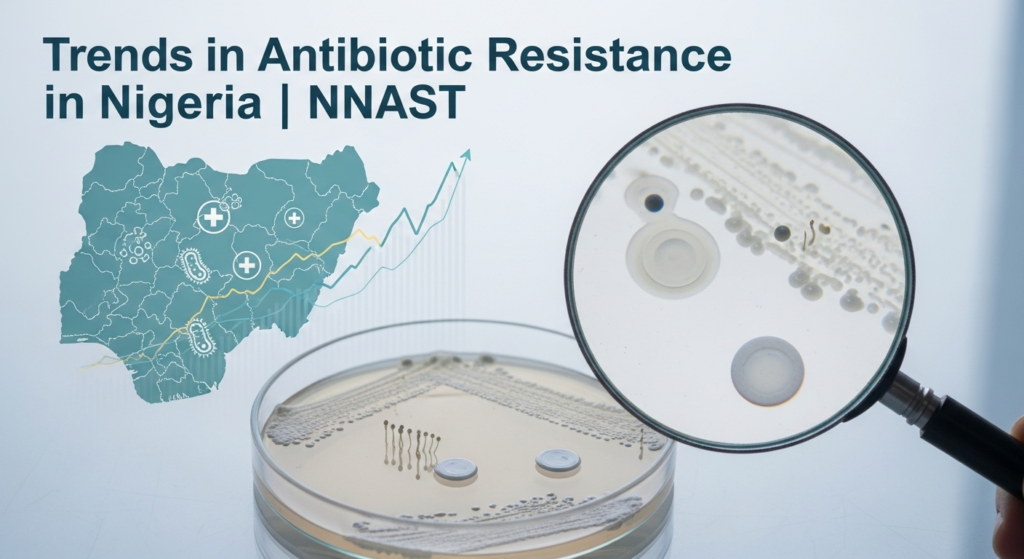
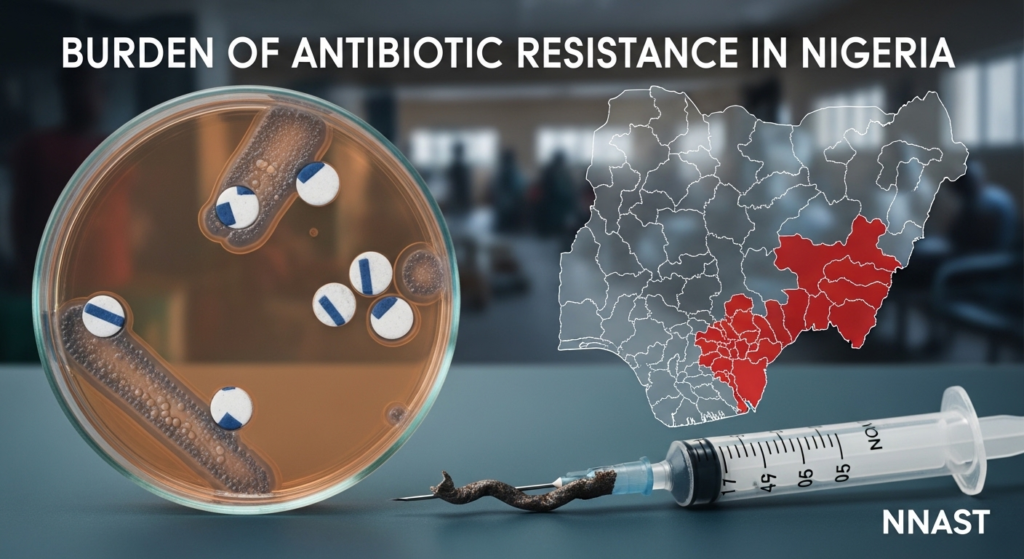

Antibiotic resistance in Nigeria has emerged as a critical public health challenge requiring urgent attention from researchers, clinicians, and policymakers. The epidemiological landscape of antibiotic resistance in Nigeria reflects complex interactions between human behavior, healthcare practices, agricultural activities, and environmental factors.
Understanding antibiotic resistance in Nigeria demands a systematic examination of resistance patterns across different bacterial species, geographic regions, and clinical settings.
Therefore, comprehensive surveillance systems are essential for tracking trends and guiding intervention strategies. Antibiotic resistance in Nigeria manifests through diverse mechanisms, including extended-spectrum beta-lactamases, carbapenemases, and methicillin resistance, each with distinct clinical and public health implications.
Epidemiology of Antibiotic Resistance in Nigeria

The epidemiology of antibiotic resistance in Nigeria encompasses the study of the distribution, determinants, and dynamics of resistance within the population. This field examines who develops resistant infections, where resistance emerges, and why certain patterns predominate.
Consequently, understanding the epidemiology of antibiotic resistance in Nigeria requires analyzing data from clinical laboratories, hospitals, and community settings. However, surveillance gaps limit comprehensive assessment in many regions.
Data Sources and Surveillance
The epidemiology of antibiotic resistance in Nigeria relies on diverse data sources. Hospital-based surveillance provides the most available information, particularly from tertiary care centers with microbiology laboratories. These facilities routinely test bacterial isolates for antibiotic susceptibility.
Additionally, research studies contribute valuable epidemiological insights. Academic institutions conduct cross-sectional surveys to examine the prevalence of resistance in specific populations or geographic areas. Nevertheless, systematic national surveillance remains limited relative to that in high-income countries.
Population Risk Factors
Several population-level factors influence the epidemiology of antibiotic resistance in Nigeria. Previous antibiotic exposure significantly increases the risk of individual resistance. Hospitalization history, particularly in intensive care units, strongly predicts carriage of resistant organisms.
Furthermore, underlying health conditions like diabetes, HIV infection, and malignancy elevate susceptibility to resistant infections. Age extremes, very young children and elderly individuals also face heightened risk.
Trends in Antibiotic Resistance in Nigeria
Trends in antibiotic resistance in Nigeria indicate generally increasing resistance rates across most bacterial species and antibiotic classes. Longitudinal studies from major hospitals demonstrate rising resistance over time, though data quality and completeness vary.
However, trends in antibiotic resistance in Nigeria are not uniformly upward. Some facilities that have implemented antimicrobial stewardship programs have reported stabilization or modest declines in specific resistance patterns, demonstrating that such interventions can be effective.
Temporal Patterns
Examining trends in antibiotic resistance in Nigeria reveals temporal patterns worth noting. Resistance to older antibiotics like ampicillin and trimethoprim-sulfamethoxazole has reached very high levels in many settings, rendering these drugs ineffective for empirical treatment.
Simultaneously, resistance to newer fluoroquinolones and third-generation cephalosporins has increased substantially over the past decade. More concerning, resistance to last-resort antibiotics like carbapenems, once rare, is becoming increasingly common.
Emerging Resistance Mechanisms
Trends in antibiotic resistance in Nigeria include the emergence of sophisticated resistance mechanisms. Carbapenemase-producing organisms, previously reported only in isolated case reports, are now detected in routine surveillance. These enzymes destroy even powerful broad-spectrum antibiotics.
Moreover, mobile genetic elements facilitate the rapid spread of resistance among bacteria. Plasmids carrying multiple resistance genes can transfer between bacterial species, accelerating the dissemination of resistance across microbial communities.
Distribution of Antibiotic Resistance in Nigeria

The distribution of antibiotic resistance in Nigeria varies considerably across geographic regions, healthcare settings, and patient populations. Urban centers typically report higher resistance rates than rural areas, likely reflecting greater antibiotic usage and healthcare intensity.
Therefore, understanding the distribution of antibiotic resistance in Nigeria helps target interventions where they are most needed and identify emerging resistance hotspots requiring urgent attention.
Geographic Variation
The distribution of antibiotic resistance in Nigeria exhibits notable geographic variation. Southern regions with higher healthcare facility density often report more resistance data, though this may reflect surveillance capacity rather than true prevalence differences.
Similarly, state capitals and major cities exhibit higher documented resistance rates than rural areas. However, limited surveillance in remote regions may underestimate resistance, particularly in regions with the poorest healthcare access.
Setting-Specific Patterns
The distribution of antibiotic resistance in Nigeria differs markedly between healthcare settings. Intensive care units consistently report the highest resistance rates, followed by surgical wards and general medical wards.
Furthermore, community-acquired infections traditionally showed lower resistance than hospital-acquired infections. However, this distinction is blurring as resistant organisms increasingly circulate in community settings through various transmission pathways.
Burden of Antibiotic Resistance in Nigeria
The burden of antibiotic resistance in Nigeria encompasses mortality, morbidity, and economic impacts. Resistant infections lead to treatment failures, prolonged illness, and higher mortality rates than susceptible infections.
Consequently, quantifying the burden of antibiotic resistance in Nigeria remains challenging due to limited surveillance infrastructure and incomplete vital registration systems. Nevertheless, available evidence indicates substantial and growing impacts.
Mortality Impact
The burden of antibiotic resistance in Nigeria is associated with significant mortality. Studies comparing outcomes between resistant and susceptible infections consistently demonstrate higher death rates with resistance. Bloodstream infections with resistant organisms carry a particularly high mortality risk.
Additionally, delayed appropriate therapy while awaiting susceptibility results contributes to poor outcomes. Each day of ineffective treatment increases the probability of mortality, making rapid diagnosis critically important.
Morbidity and Complications
Beyond mortality, the burden of antibiotic resistance in Nigeria includes substantial morbidity. Resistant infections are associated with longer illness duration, more complications, and greater disability. Patients may require more invasive procedures or intensive monitoring.
Furthermore, treatment-related toxicity from second-line antibiotics adds to the morbidity burden. Aminoglycosides can cause permanent hearing loss and kidney damage. Other reserve antibiotics carry risks of allergic reactions, organ toxicity, and other adverse effects.
Prevalence of Antibiotic Resistance in Nigeria

The prevalence of antibiotic resistance in Nigeria varies across bacterial species, antibiotic classes, and clinical settings. Overall, resistance rates to commonly used antibiotics are concerningly high across most pathogen groups.
However, accurately measuring the prevalence of antibiotic resistance in Nigeria requires representative sampling across diverse populations and settings. Current data predominantly comes from tertiary hospitals, potentially overestimating national prevalence.
Gram-Negative Bacteria
The prevalence of antibiotic resistance in Nigeria is particularly high among Gram-negative bacteria. Escherichia coli, Klebsiella pneumoniae, and Pseudomonas aeruginosa are commonly multidrug-resistant. ESBL production rates often exceed 50% in many facilities.
Moreover, carbapenem resistance, although still relatively uncommon, exhibits concerning trends. Some hospitals report carbapenem resistance rates approaching 20-30% in Klebsiella pneumoniae, severely limiting treatment options.
Gram-Positive Bacteria
Among Gram-positive organisms, antibiotic resistance in Nigeria is prevalent, with significant MRSA rates. Prevalence ranges from 20% to 60%, depending on the facility and patient population. Surgical units often report higher rates than medical wards.
Similarly, resistance in Enterococcus species is increasing, including some vancomycin-resistant strains. These organisms pose particular challenges in abdominal and urinary tract infections.
Antibiotic Resistance Patterns in Nigeria

Antibiotic resistance patterns in Nigeria reveal systematic trends in which antibiotics remain effective and which have lost utility. These patterns guide empirical therapy decisions and inform stewardship strategies.
Therefore, continuous monitoring of antibiotic resistance patterns in Nigeria is essential to update treatment guidelines and preserve the remaining effective antibiotics through judicious use.
Class-Specific Patterns
Antibiotic resistance patterns in Nigeria show class-specific characteristics. Beta-lactam resistance is widespread, particularly among Gram-negative bacteria. Fluoroquinolone resistance has increased dramatically over the past decade.
Additionally, aminoglycoside resistance varies by both the specific drug and the organism. Gentamicin resistance is common, while amikacin may retain better activity. However, toxicity concerns limit aminoglycoside use.
Multidrug Resistance
Concerning antibiotic resistance patterns in Nigeria, multidrug resistance is increasing. Organisms resistant to three or more antibiotic classes are becoming commonplace. Some extensively drug-resistant strains are resistant to all but one or two available antibiotics.
Furthermore, pan-resistant organisms, those resistant to all tested antibiotics, occasionally emerge. These represent worst-case scenarios in which no conventional treatment options remain, necessitating reliance on experimental therapies or combinations.
FAQs
What bacterial species show the highest antibiotic resistance rates in Nigeria?
Several bacterial species exhibit particularly high rates of antibiotic resistance in Nigeria. Among Gram-negative bacteria, Klebsiella pneumoniae and Escherichia coli commonly produce extended-spectrum beta-lactamases (ESBLs), with prevalence often exceeding 50% in hospital settings.
How does antibiotic resistance prevalence in Nigerian hospitals compare to community settings?
Traditionally, hospital settings have reported substantially higher rates of antibiotic resistance than community settings in Nigeria. Intensive care units show the highest resistance rates, followed by general hospital wards. However, this distinction is becoming less clear as resistant organisms circulate more widely in communities.
What resistance mechanisms are most common in Nigeria, and why do they matter clinically?
The most common resistance mechanisms in Nigeria include extended-spectrum beta-lactamases (ESBLs), which hydrolyze many beta-lactam antibiotics; methicillin resistance in Staphylococcus aureus; and increasingly, carbapenemases that destroy even last-resort carbapenems.



